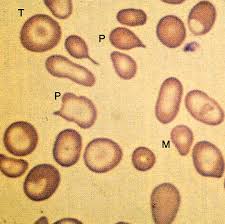

La beta talassemia maior, anche conosciuta come Morbo di Cooley, è una condizione molto grave che si manifesta in omozigosi dando anemia molto severa.
La patogenesi è legata alla ridotta o assente sintesi delle catene beta della globina, che determina una ridotta o assente sintesi di HbA1 (alfa2 beta2) ed un eccesso di catene alfa2 libere che precipitano formando corpi di inclusione che si fissano alla membrana eritrocitaria danneggiandola, di conseguenza si ha lisi eritroblastica ed una ridotta sopravvivenza degli eritrociti maturi a 20 - 30 giorni.
Ciò si accompagna ad un eccesso di HbF (alfa2 gamma2) prodotta da eritroblasti che derivano da cellule staminali che non hanno soppresso la sintesi di catene gamma e la cui sopravvivenza è favorita dalla riduzione delle catene beta. L'aumento dell'emoglobina fetale HbF è un marker fenotipico del Morbo di Cooley.
La diagnosi viene spesso fatta entro i primi 6 mesi di vita per le manifestazioni cliniche con cui si manifesta questa patologia:
- Grave anemia congenita cronica: pallore
- Ittero
- Splenomegalia: per iperplasia della polpa rossa da esaltata emarginazione e distruzione eritrocitaria
- Inappetenza
- Dispepsia
- Epatomegalia: per lo sviluppo di un'emopoiesi extramidollare
- Sviluppo somatico e sessuale incompleto e ritardato
- Rarefazione delle ossa con assottigliamento della corticale ed iperplasia spongiosa
- Cranio a spazzola
- Facies simil asiatico
- Sintomi e segni di danni d'organo per deposizione tissutale di ferro (emocromatosi)
Dati di laboratorio:
- Anemia molto grave con concentrazione di Hb di 4-6 g / dl
- Basso numero di eritrociti che sono fortemente ipocromici e morfologicamente alterati:
- Anisopoichilocitosi
- Leptocitosi
- Schistocitosi
- Forme bizzarre
- Eritrociti a bersaglio
- Leucociti e piastrine normali
- La mielobiopsia mostra iperplasia eritroblastica con segni citologici della diseritropoiesi ed aumentata quantità emosiderinica
- Aumento della bilirubinemia
- Diminuzione della vita media degli eritrociti
Il decorso è spesso complicato dalle conseguenze della terapia trasfusionale cronica:
- Emosiderosi secondaria
- Trasmissione di malattie virali
- Trattamento trasfusionale per mantenere l'Hb tra i 9 - 10 g/dl
- Chelanti del ferro: per rimediare all'accumulo di ferro che si può determinare con l'emotrasfusione
- Desferroxamina B: la dose ideale si calcola in base alla quantità di sangue trasfuso ed alla quantità di ferro escreta con le urine. Piccole dosi di acido ascorbico aumentano l'efficacia del farmaco.
- Splenectomia
- Trapianto di midollo osseo allogenico da donatore familiare.
Immagini by emedicine
Nessun commento:
Posta un commento